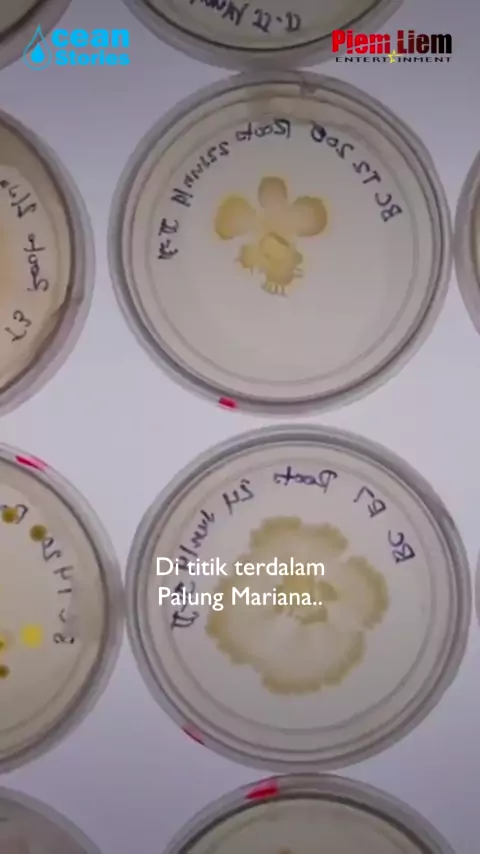

Kalian Tahu?

1.2K
Posts

All playlists · Total 107

3
Nihh film yang diadaptasi dari novel best seller PART 1 #poldark #kaliantau #pengetahuan #news #ilmu #viral #trending #KEPO

2
Ngerjain artis ibu kota #kaliantahu #pengetahuan #news #ilmu #viral #trending #kepo #kilauparty #ramadanmubarak #ramadan2022

2
Beberapa Film kartun Malaysia yang laris di Indonesia #kaliantahu #pengetahuan #news #ilmu #viral #trending #kepo #snack17an

2
Hmmm gak nyangka sih bisa meroket gini #kaliantau #pengetahuan #news #ilmu #viral #trending #KEPO

3
Serunya Lomba Dayung di IFG Labuan Bajo Marathon 2022 #kaliantahu #pengetahuan #news #ilmu #viral #trending #kepo #snack17an

3
Sang Peneliti Musabab BERI-BERI #kaliantahu #pengetahuan #news #ilmu #viral #trending #kepo #snack17an

3
Asal Mula Main Permainan Petak Umpet | Asal Usul #kaliantahu #pengetahuan #news #ilmu #viral #trending #kepo #snack17an

4
Kenapa Supporter Sepakbola Lebih Banyak Dibandingkan Olahraga Lain ? | #kaliantahu #pengetahuan #news #ilmu #viral #trending #kepo #snack17an

9
Atlet atlet Dunia Yang Pernah Alami Gangguan Mental #kaliantahu #pengetahuan #news #ilmu #viral #trending #kepo #snack17an

6
Ikan Nun atau "Zun Nun", adalah paus biru.. #kaliantahu #pengetahuan #news #ilmu #viral #trending #kepo #snack17an

2
Asal Mula Jas Hujan Ditemukan #kaliantahu #pengetahuan #news #ilmu #viral #trending #kepo #snack17an

2
Kompilasi Fakta Penting Gak Penting #kaliantahu #pengetahuan #news #ilmu #viral #trending #kepo #snack17an

2
Kompilasi Penampakan Makhluk Misterius Paling Mengerikan #kaliantahu #pengetahuan #news #ilmu #viral #trending #kepo #snack17an

2
TELUR DI JEPANG BEBAS SALMONELLA? #kaliantahu #pengetahuan #news #ilmu #viral #trending #kepo #snack17an

2
Semua Orang Bisa Jadi Jenius ? #kaliantahu #pengetahuan #news #ilmu #viral #trending #kepo #snack17an

3
Saat Tentara Jepang dan Pribumi Menggempur Belanda di Sumatera #kaliantahu #pengetahuan #news #ilmu #viral #trending #kepo #snack17an

22
Kalian hapal gak plat nomer dari seluruh Indonesia??? WKWKK pasti kalian baru tahu kannn? #kaliantahu #pengetahuan #news #ilmu #viral #trending #kepo

16
Kalian tahu gak sih? Dollar Amerika udah mulai disingkirkan #kaliantau #pengetahuan #news #ilmu #viral #trending #KEPO

20
Kalian tau gakk ternyata ini fakta unik dari pecahan rupiah yang baru viral #kaliantau #pengetahuan #news #ilmu #viral #trending

3
KALIAN TAHU? INI merupakan beberapa fakta unik semut #kaliantau #pengetahuan #news #ilmu #viral #trending